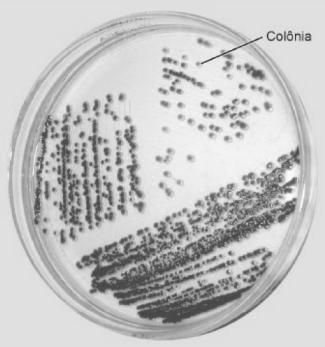
Enunciado 4860992-1

Disciplina: Técnicas em Laboratório
Banca: OBJETIVA
Orgão: Pref. Francisco Alves-PR
As técnicas mais comuns para isolamento de microrganismos em cultura pura são o esgotamento e as diluições em placas. Ambas se baseiam no princípio de que uma célula microbiana isolada, ou um único esporo, quando depositados em um meio de cultura sólido adequado, resultará em um agrupamento macroscopicamente visível chamado colônia. A figura abaixo mostra uma dessas técnicas.
Considerando o exposto, assinalar a alternativa que preenche as lacunas abaixo CORRETAMENTE.
A técnica de esgotamento em _____________ é adequada para ______________ de microrganismos.
Fonte: Alane Beatriz Vermelho, Antônio Pereira, Rosalie Coelho, Thaïs SoutoPadrón. Práticas de Microbiologia.